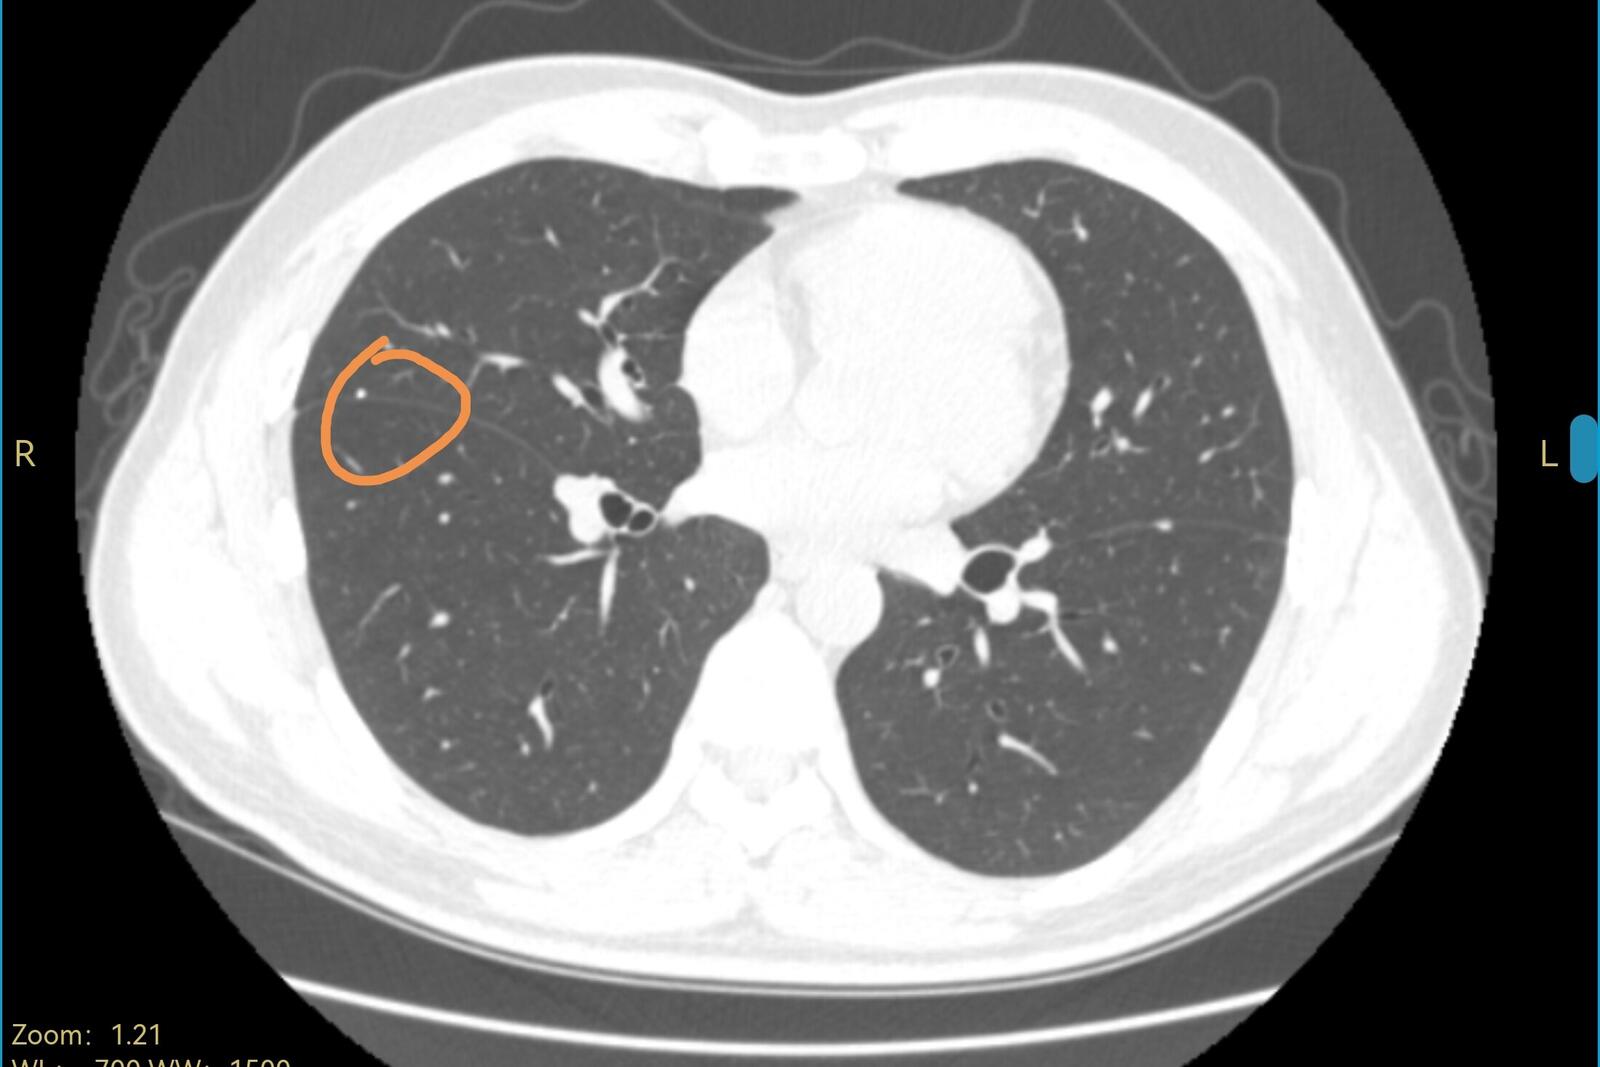
刘懿博士说肺癌的书,刘懿博士说肺癌全集

今天是周六,天津的天气很阴沉,下午还下起了小雨,祝愿各位朋友周末愉快。今天在线上问诊平台接受了几位肺结节患者的咨询,今天的这几位肺结节患者以年轻的朋友居多。
有一位家住天津34岁的男士前两天刚在我们医院拍了胸部CT,发现了肺部有结节,想让我看一看结节的性质。他说自己夏天得了鼻炎,一直打喷嚏,鼻子痒。十一期间,他作为基层工作者在疫情防控工作中要穿大白,也就是防护服,穿上之后一吸气,就感觉自己右侧胸口疼,到现在偶然还是有这种症状,于是就到我们医院医院拍了胸部CT,一看报告,肺里面有两个结节,在线上找我咨询。
我看到了他的电脑图像,肺里面这两个结节,一左一右,都是在叶裂之间,直径都很小,右边那个结节是有钙化的,左边那个结节虽然没有钙化,但看起来像是个肺表面的淋巴结,这两个结节都考虑是良性,可以继续观察。CT上也没有其他可以解释胸口疼的表现,我请他再观察一下,也许不知道是怎么样抻了一下引起的疼痛。

图片描述

图片描述
图片描述